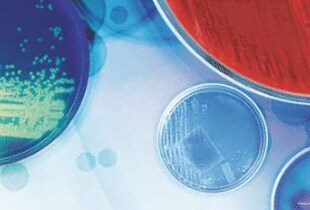

News that the Omicron surge is subsiding is more than welcom...
Read More Protecting Your Workforce When a Pandemic Becomes Endemic
Where inquisitive minds come to learn about the basics of science, scientific research, medicine and more.
Where inquisitive minds come to learn about the basics of science, scientific research, medicine and more.

News that the Omicron surge is subsiding is more than welcom... by Ask A Scientist Staff / 04.18.2022
Read More Protecting Your Workforce When a Pandemic Becomes Endemic
As the United States begins to loosen COVID-19 restrictions,... by Ask A Scientist Staff / 04.27.2021
Read More COVID-19 vaccines are here, but so are the variants, so testing is more Important than ever
As more and more people get vaccinated, it might seem logica... by Ask A Scientist Staff / 04.19.2021
Read More Preventing “Silent Spread”: Why Asymptomatic Testing is Crucial During Vaccine Rollout
You may be among the millions of people whose homes have bec... by Ask A Scientist Staff / 04.05.2021
Read More Four ways companies can make the workplace safer from the SARS-CoV-2 virus
qPCR stands for quantitative polymerase chain reaction and i... by Ask A Scientist Staff / 02.07.2020
Read More What is qPCR?
Cancer is a collection of related diseases caused by ... by Ask A Scientist Staff / 11.15.2019
Read More What is Cancer?
Stem cells are cells that can divide into multiple ki... by Ask A Scientist Staff / 11.01.2019
Read More What are Stem Cells?
RNA stands for ribonucleic acid, a nucleic acid prese... by Ask A Scientist Staff / 09.30.2019
Read More What is RNAi?
Molecular biology is the branch of biology that studies the ... by Ask A Scientist Staff / 09.03.2019
Read More What is Molecular Biology?